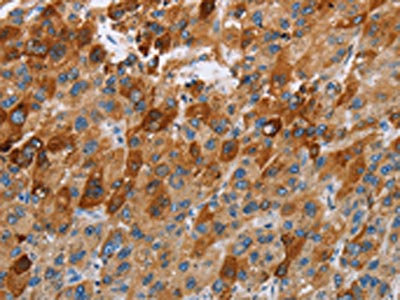

CCR9 Antibody
-
中文名稱:CCR9兔多克隆抗體
-
貨號:CSB-PA293047
-
規格:¥1100
-
圖片:
-
The image on the left is immunohistochemistry of paraffin-embedded Human liver cancer tissue using CSB-PA293047(CCR9 Antibody) at dilution 1/40, on the right is treated with fusion protein. (Original magnification: ×200)
-
The image on the left is immunohistochemistry of paraffin-embedded Human thyroid cancer tissue using CSB-PA293047(CCR9 Antibody) at dilution 1/40, on the right is treated with fusion protein. (Original magnification: ×200)
-
-
其他:
產品詳情
-
Uniprot No.:
-
基因名:
-
別名:CCR9; GPR28; C-C chemokine receptor type 9; C-C CKR-9; CC-CKR-9; CCR-9; G-protein coupled receptor 28; GPR-9-6; CD antigen CDw199
-
宿主:Rabbit
-
反應種屬:Human,Mouse
-
免疫原:Fusion protein of Human CCR9
-
免疫原種屬:Homo sapiens (Human)
-
標記方式:Non-conjugated
-
抗體亞型:IgG
-
純化方式:Antigen affinity purification
-
濃度:It differs from different batches. Please contact us to confirm it.
-
保存緩沖液:-20°C, pH7.4 PBS, 0.05% NaN3, 40% Glycerol
-
產品提供形式:Liquid
-
應用范圍:ELISA,IHC
-
推薦稀釋比:
Application Recommended Dilution ELISA 1:2000-1:5000 IHC 1:50-1:200 -
Protocols:
-
儲存條件:Upon receipt, store at -20°C or -80°C. Avoid repeated freeze.
-
貨期:Basically, we can dispatch the products out in 1-3 working days after receiving your orders. Delivery time maybe differs from different purchasing way or location, please kindly consult your local distributors for specific delivery time.
-
用途:For Research Use Only. Not for use in diagnostic or therapeutic procedures.
相關產品
靶點詳情
-
功能:Receptor for chemokine SCYA25/TECK. Subsequently transduces a signal by increasing the intracellular calcium ions level.; (Microbial infection) Alternative coreceptor with CD4 for HIV-1 infection.
-
基因功能參考文獻:
- There were significantly increased CCR9 protein levels in failing human hearts. PMID: 27146447
- this study showed that CCR7 are overexpressed in CD4(-) CD8(-) thymocytes of myasthenia gravis patients. PMID: 26616645
- Results indicated that the expression levels of CCR9 in lesional skin may be a useful biologic marker of the clinical efficacy of infliximab therapy in psoriasis patients. PMID: 26507968
- Xray crystal structure of the CCR9 receptor in complex with vercirnon at 2.8 A resolution PMID: 27926729
- It plays a pathogenic role in liver diseases and it will be a therapeutic target of the diseases. PMID: 27795503
- that CCL25/CCR9 signal may provide cancer cells with chemotactic abilities through influencing several epithelial-mesenchymal transitionmarkers PMID: 27008282
- Studies indicate important roles played by chemokine ligand 25 (CCL25)/chemokine receptor 9 (CCR9) in tumorigenesis, tumor chemoresistance and metastasis. PMID: 26879872
- CCR9 and Integrin-beta7 expression has a differential effect on graft fate during acute graft-versus-host disease (GVHD) of the liver depending on the GVHD target tissue. PMID: 26348893
- CCR9 mRNA and protein levels were significantly increased in the nasopharyngeal carcinoma group compared with the control group. PMID: 26279399
- CCR9-CCL25 interaction promoted proliferation and suppressed apoptosis of non-small cell lung cancer cells by activating the PI3K/Akt pathway. PMID: 25691296
- CCR9 could be beneficial in predicting lymph node metastasis, and it might act as a novel prognostic biomarker for lung adenocarcinoma. PMID: 26168791
- We also show that primary tumors can be modeled in immunocompetent mice by microinjecting CCR9-expressing cancer cell lines into early-stage mouse blastocysts, which induces central immune tolerance PMID: 26006007
- High CCR9 expression is associated with the pathogenesis of ulcerative colitis. PMID: 24936795
- Expression of CCR9 and CCL25, the only natural ligand of CCR9, was significantly higher (p<0.0001) in NSCLC tissues and serum respectively, compared to their respective controls. PMID: 25296976
- activation of Notch1 has a dominant-negative effect on Ccr9 transcription and that Notch1 and E proteins control the dynamic expression of Ccr9 during T cell development. PMID: 25710912
- The results show the potential of the 91R monoclonal antibody as a therapeutic agent for treatment of CCR9-expressing tumors. PMID: 24870448
- results suggest that CCR9 can act as a novel prognostic marker and therapeutic target for hepatocellular carcinoma PMID: 24481516
- CCR9 expression is elevated in the nodal lymphomas of patients with GI involvement PMID: 24828696
- Only rotavirus specific CD4 T cells expressed intestinal homing receptors alpha4beta7 and CCR9. PMID: 24606696
- Data suggest that P-glycoprotein associate with the F-actin cytoskeleton through ezrin/radixin/moesin (ERM) in CCR9/CCL25 induced multidrug resistance of acute T-lymphocytic leukemia (T-ALL) cells. PMID: 23326330
- Notch1 regulates chemotaxis and proliferation by controlling the CC-chemokine receptors 5 and 9 in T cell acute lymphoblastic leukaemia. PMID: 21984373
- We provide the first evidence that CCR9 and its natural ligand CCL25 are highly expressed by ovarian cancer tissue and their expression correlates with histological subtypes. PMID: 21637913
- CCL25 enhanced the expression of MMP-1, -9, -11 and -13 active proteins by BrCa cells in a CCR9-dependent fashion. PMID: 21344163
- CCR9+ Th cells are a subset of IL-21-producing T helper cells that influence regional specification of autoimmune diseases that affect accessory organs of the digestive system PMID: 21511186
- The high fraction of circulating IgA+ and IgG+ B cells expressing CCR9 and CCR10 in the first months of life indicates activation of naive B cells in the gut, coinciding with bacterial colonization. PMID: 21075690
- TLR2 ligands induce CCR9 and CCR10 expression by circulating B-cells and increase their chemotaxis. TLR2 stimulation also induced J chain and IgA production demonstrating the induction of mucosal-like antibody secreting cells. PMID: 20947433
- CCR9 expression by monocytes is increased in rheumatoid arthritis PMID: 20738854
- Results demonstrate enhanced pancreatic intraepithelial neoplasia and pancreatic cancer cell proliferation with activation of CCR9 by its selective ligand CCL25 PMID: 19756884
- Studies indicate that D6 chemokine receptor(CCR-9) may act as scavenging decoys and are involved in clearance of chemokines. PMID: 20036838
- more active homing of CCR9-926AG T cells to Peyer's patches may produce changes in Ag presentation and result in increased incidence of skin graft vs. host disease. PMID: 19525985
- over-expressed TECK interacts with CCR9 on the endometrial stromal cells in the endometriotic milieu, which may contribute to the onset and progression of endometriosis. PMID: 20081876
- A subset of CCR9+ T cells from normal donors has characteristics of mucosal T cells in terms of activated phenotype, proliferative response to anti-CD2 stimulation, a Th1 or Tr1 cytokine profile, and support for Ig production by cocultured B cells. PMID: 12816994
- CCR9 selectively induced T-ALL CD4+ T-cell chemotaxis and adhesion. PMID: 14559839
- High Expression of CCR9 is associated with prostate cancer cell migration and invasion PMID: 15623660
- involved in the pathogenesis of lymphatic filarial disease PMID: 15717282
- CCR9 overexpression is associated with Adult T-cell leukemia cells infiltrating gastrointestinal tract PMID: 17205512
- CCR9 expression is reduced on epithelial and lamina propria T cells in untreated celiac disease. Down-regulation of CCR9 persists in intraepithelial T cells from well-treated patients. Possible ongoing immune activation preferentially within epithelium. PMID: 17570212
- CCR9 is expressed on human melanoma cells and participates in the enhanced motility of melanoma cells and is likely a "homing receptor" for melanoma to the small bowel. PMID: 18245518
- Functionally active CCR9 on melanoma cells facilitates metastasis to the small intestine which may explain high incidence of metastis to the small intestine. PMID: 18245522
顯示更多
收起更多
-
亞細胞定位:Cell membrane; Multi-pass membrane protein.
-
蛋白家族:G-protein coupled receptor 1 family
-
組織特異性:Highly expressed in the thymus and low in lymph nodes and spleen.
-
數據庫鏈接:
Most popular with customers
-
-
YWHAB Recombinant Monoclonal Antibody
Applications: ELISA, WB, IHC, IF, FC
Species Reactivity: Human, Mouse, Rat
-
Phospho-YAP1 (S127) Recombinant Monoclonal Antibody
Applications: ELISA, WB, IHC
Species Reactivity: Human
-
-
-
-
-